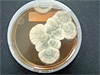

Третий мир жизни

Если организм Physarum polycephalum три раза подряд класть в холодильник через каждые десять минут, то на четвертый раз он сам уже замрет в ожидании холода,—доктор Тэцу Саигуса из Университета Хоккайдо хищно ухмыльнулся и даже попытался жестами изобразить, как ежится от мороза кусочек плесени в чашке Петри.—Конечно, со временем плесень забывает свой опыт. Но стоит ей лишь напомнить о неприятностях, немного понизив температуру, как «память» о холоде снова вернется, и через определенный временной интервал она снова будет уменьшаться в размерах, даже если мы оставим ее в покое…»
Вот именно таким нехитрым способом японцы и обнаружили у плесени зачатки разумного поведения. Правда, объяснить, откуда в одноклеточном организме взялась способность анализировать ход событий, наука пока не в состоянии. Впрочем, доктор Тэцу Саигуса предложил свою модель, объясняющую поведение плесени: в гигантской клетке Physarum polycephalum, способной разрастись в огромный «блин» объемом в пару кубических метров, есть множество биохимических «маятников» с разнообразными периодами. Одни «маятники» ускоряют движение организма, другие—замедляют его. А вот когда внешние условия меняются, то процессы, ускоряющие движение в неподходящий момент, отключаются—на них в холоде и сухости тратится слишком много ресурсов. Несколько ритмичных «ударов судьбы»—и в организме активными остаются лишь те маятники, что в нужный момент замедляют ход. Это состояние некоторое время сохраняется, и свой ход слизь замедляет независимо от того, наносит ли судьба удары. Приблизительно по такому же принципу работает и мозг человека.
ПЛЕСЕНЬ ПРАВИТ МИРОМ
Человечество окружает удивительный микромир, обитателей которого порой не рассмотришь без микроскопа. Тем не менее эти малютки способны думать, заполнять собой пространство, выживать в космосе, «зимовать» миллион лет в Арктике, менять среду под свои потребности. Обитатели этого мира—грибы—не относятся ни к фауне, ни к флоре, это не животные и не растения. С растениями их сближает привязанность к месту рождения, с животными—питание органикой, ведь грибы не занимаются фотосинтезом углеводов, а питаются остатками органики в почве. По сути, это третья форма жизни. Они могут быть одновременно и лекарством, и возбудителем заболевания. Бывают очень красивы на вид, но вызывают отвращение, появляясь в нашем доме. Они невидимы и при этом пронизывают пространство насквозь во всех частях света. «Там, где нет плесени, нет жизни»,—говорит Пол Даер, доктор биологии, профессор Университета Ноттингема.
Плесень оказалась настолько важной персоной, что Первый канал с громкой помпой презентовал фильм «Плесень», снятый Саидой Медведевой, которая сделала парадоксальный вывод: на самом деле на Земле господствует плесень, а не человек. Она окружает нас с рождения до смерти, она была всегда и, судя по всему, всегда будет—даже если случится ядерная война, всемирный потоп или наступит вечная мерзлота.
—Мы специально выращивали плесень в студии, пока снимали фильм, чтобы показать, как она зарождается, как растет, как разлетаются невидимые глазу споры,—рассказывает Саида Медведева,—и сразу же ощутили на себе влияние этих спор—большая часть съемочной группы переболела в процессе работы. Это было похоже на локальную эпидемию. К счастью, пока снимался фильм, Светлана Чубатова, доктор биологических наук и наш научный консультант, открыла действие монарды (растение из Северной Америки.—«О») на плесень вида Aspergillus—один из самых патогенных грибков. Мы проверили действие эфирного масла монарды прямо в студии, и «плесневелая эпидемия» закончилась в течение трех дней.
И НЕ ДРУГ, И НЕ ВРАГ
Мы привыкли—если заплесневело, значит, испортилось. А на факультете почвоведения МГУ ученые специально разводят плесень. Она растет в чашках Петри—белая, пушистая, как вата, серо-голубая с темно-зелеными прожилками, оранжевая с бордовым ободком в виде пятен правильной формы, черная и ворсистая, изумрудная с прозрачными янтарно-желтыми каплями посередине плесневелого круга.
—Это выделение грибов,—объясняет профессор Ольга Марфенина с кафедры почвоведения МГУ,—во время развития они выделяют продукты своей жизнедеятельности.
Изучение плесени поможет ученым понять, как отражается вмешательство человека в равновесие неизвестной пока науке системы микроорганизмов. Ведь антропогенная деятельность меняет не только внешний вид окружающей среды, но и ее химический состав, и плесень может служить одним из индикаторов сохранности изначальных природных условий.
—В норме в каждом месте на Земле—от тундры до тропических лесов—существует определенное сочетание видов плесени, их количество,—говорит профессор Ольга Марфенина.—Формируется «плесневелый показатель» сравнительно долго, в нем «учтены» все особенности местности. Сведение леса распашкой земель, удобрение почвы, загрязнение тяжелыми металлами—на каждый фактор мы имеем реакцию плесени. Но самое сильное влияние на микромир оказывает урбанизация.
—В городах плесень исчезает?
—Вовсе нет. В городе развиваются другие виды плесени—куда более агрессивные. В мегаполисе грибкам приходится развиваться в более трудных условиях, среди стекла, пластика и выхлопных газов. И она приспосабливается выживать на чем угодно—даже на стекле.
—Это значит—более устойчивая плесень становится более опасной?
—Я бы сказала, что выживает больше видов, потенциально опасных для человека.
—Но в чистом проветриваемом помещении наверняка никакой плесени нет…
—Вот в этом кабинете, где мы с вами сейчас разговариваем, в одном кубическом метре воздуха сотни грибных единиц в виде спор. Плесневые грибы отличаются потрясающей плотностью при очень маленьких размерах—всего несколько микрон. А если брать почву—в одном только грамме мы обнаружим тысячи спор и сотни метров мицелия. Я это называю микологической, то есть «грибной», средой обитания человека. Всем известно, что нас изнутри и снаружи окружают бактерии, полезные и вредные. Точно так же и вокруг человека и внутри его живут микрогрибы. Или, как называют в простонародье—плесень.
Однако даже агрессивная плесень не наносит вреда человеческому организму, если нормально работает иммунитет. На первом месте по вирулентности, то есть болезнетворности, стоят вирусы и бактерии. Плесени находятся в черном списке намного дальше.
—Заболевания, вызываемые плесневелыми грибами, называют микозами,—говорит Ольга Марфенина.—Чаще всего они поражают людей, больных СПИДом,—ведь их иммунитет не в состоянии противостоять воздействиям среды. Также в группу риска попадают люди с тяжелыми системными заболеваниями, обширными ожогами, зараженные радиацией.
С микозами трудно бороться, во-первых, колонии крошечных спор в организме проблематично обнаружить, во-вторых, плесневые грибы обладают очень высокой резистенцией, или, проще говоря, устойчивостью, и очень быстро размножаются, поражая всю доступную площадь. Чаще всего в быту встречаются микозы стоп—грибковые заболевания, которые можно подхватить в бассейне или бане, если ходить в общем зале босиком. Впрочем, самый большой вред плесневелые грибы наносят человеку опосредованно—поражая продукцию сельского хозяйства. В 60-х годах в Британии из-за повального заражения кормов разразилась эпидемия среди домашней птицы, и всех кур пришлось пустить под нож. Убытки составили миллионы фунтов стерлингов.
Человек пытается отгородиться от микромира, обезопасить себя. Так, российские ученые из института токсикологии создали полимер, отталкивающий бактерии. Но бывает, что именно техника, призванная очистить помещение, сделать его свежим и безопасным, служит распространению микроорганизмов.
—Это касается в первую очередь кондиционеров,—говорит биолог Светлана Чубатова,—если фильтры в них не чистить регулярно, на волокна фильтров садятся бактерии и образуют так называемую биопленку. Если вы посмотрите на нее под микроскопом, вы увидите, какая она шероховатая. И на этой пленке вполне могут развиваться колонии плесневелых грибов. И уничтожить их практически невозможно.
—В чем же секрет такой ее устойчивости?
—Споры грибов содержат очень мало воды, имеют очень прочную оболочку, способны храниться миллионы лет в любых условиях. Наши ученые находили споры грибов даже в Антарктиде и Арктике—после миллионов лет «хранения» во льдах плесневые споры удалось «разбудить» и они стали размножаться. Так же успешно плесень справляется с радиацией—это показали образцы плесени, взятые в Чернобыле прямо из-под саркофага. Плесень благополучно выжила в открытом космосе в рамках эксперимента «Биориск».
ПЛЕСЕНЬ НА РАБОТЕ
Впрочем, плесневелые грибки могут быть не только врагом человека, но и его надежным помощником, вырабатывая массу полезных веществ, работая биофабриками.
—Сегодня мы получаем из плесени около двух десятков лекарственных препаратов,—рассказал «Огоньку» Пол Даер, профессор Ноттингемского университета.—Это антибиотики, медикаменты для беременных женщин, так называемые статики—препараты для снижения холестерина. Кроме того, плесневелые грибы обладают одной особенностью—они выделяют в окружающую среду продукты своей жизнедеятельности, меняя среду под себя.
Перерабатывая некий субстракт, плесень может давать в виде «отходов» полезные для человека вещества. Например, пигменты для косметической промышленности, биотопливо.
Так или иначе, но человеку теперь придется куда более внимательно относиться к соседям из микромира. Ведь если они разумны, то нам наверняка со временем придется как-то налаживать контакты.
ЦЕННАЯ ГНИЛЬ
ПЛЕСЕНЬ ДАЛА ЧЕЛОВЕЧЕСТВУ ПРОДУКТЫ, БЕЗ КОТОРЫХ СЕГОДНЯ СЛОЖНО ПРЕДСТАВИТЬ НАШУ ЖИЗНЬ
СЫР
 «Голубые» сыры, например французский рокфор, итальянский горгонзола и английский стилтон, получают с помощью плесени вида Penicillium roqueforti. сначала на хлебе выращивают плесень, которую затем сушат, превращают в порошок и добавляют в сыр, прокалывая его длинными спицами, зараженными плесенью—уже в процессе формовки.
«Голубые» сыры, например французский рокфор, итальянский горгонзола и английский стилтон, получают с помощью плесени вида Penicillium roqueforti. сначала на хлебе выращивают плесень, которую затем сушат, превращают в порошок и добавляют в сыр, прокалывая его длинными спицами, зараженными плесенью—уже в процессе формовки.
КЕФИР
 Из кисломолочных продуктов самый популярный—кефир—получают с помощью кефирных грибков: целой группы разных стрептококков, палочек, бактерий и дрожжей. Именно эти микроорганизмы и борются с патогенной для человеческого организма микрофлорой.
Из кисломолочных продуктов самый популярный—кефир—получают с помощью кефирных грибков: целой группы разных стрептококков, палочек, бактерий и дрожжей. Именно эти микроорганизмы и борются с патогенной для человеческого организма микрофлорой.
ХЛЕБ
 Люди догадались использовать грибок для изготовления теста еще во времена неолита, но споры о пользе дрожжевого хлеба не утихают и по сей день. Однако микробиологи объясняют, что дрожжевой грибок S. cerevisiae, используемый также в хмелевых заквасках, является постоянной составной частью микрофлоры здорового человека.
Люди догадались использовать грибок для изготовления теста еще во времена неолита, но споры о пользе дрожжевого хлеба не утихают и по сей день. Однако микробиологи объясняют, что дрожжевой грибок S. cerevisiae, используемый также в хмелевых заквасках, является постоянной составной частью микрофлоры здорового человека.
ВИНО
 Венгерское «Токай» и сотернские вина Франции получают с помощью плесени вида Botrytis cinerea. Это очень сложный процесс. Грибок должен поселиться на ягодах, но при этом ягоды должны оставаться целыми, чтобы мякоть не соприкасалась с воздухом. Завядшие под воздействием плесени виноградины содержат уже не сок, а концентрированный нектар.
Венгерское «Токай» и сотернские вина Франции получают с помощью плесени вида Botrytis cinerea. Это очень сложный процесс. Грибок должен поселиться на ягодах, но при этом ягоды должны оставаться целыми, чтобы мякоть не соприкасалась с воздухом. Завядшие под воздействием плесени виноградины содержат уже не сок, а концентрированный нектар.
ЛЕКАРСТВО
Пенициллин—первый антибиотик, полученный в 1928 году на основе плесени Penicillium. Открытие произошло случайно— биолог Александр Флеминг забыл чашку Петри с высаженными стафилококками. Позже ученый обнаружил, что плесень полностью уничтожила болезнетворные бактерии.
Пенициллин—первый антибиотик, полученный в 1928 году на основе плесени Penicillium. Открытие произошло случайно— биолог Александр Флеминг забыл чашку Петри с высаженными стафилококками. Позже ученый обнаружил, что плесень полностью уничтожила болезнетворные бактерии.

